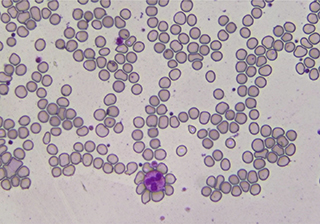
血細(xì)胞

搜索結(jié)果: 36
偏振光下水合萜二醇
1696
工業(yè)測量
1820
偏光骨骼組織切片
1730
腎臟細(xì)胞
1647
神經(jīng)元細(xì)胞
1544
果蠅效果圖
1567
醫(yī)療病理組織
1836
老鼠組織切片
1634
體視觀察
1780
血細(xì)胞
1525
鮮花
1578
骺板骨形成
2057
彈性纖維
1693
彩色組織切片 -TrueChrome HDMI 相機(jī)
2035
彩色病理切片
1739
電路板
1517
電路板
1593
明場細(xì)胞成像
1579
明場基礎(chǔ)骨骼切片
1614
血細(xì)胞成像 - TrueChrome HDMI 相機(jī)
1445